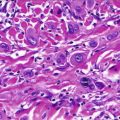

Fig. 46.1
Desmoplastic melanoma. An ill-defined indurated plaque on the back of a 60-year-old female. Pigmentation and signs of regression suggest the diagnosis

Fig. 46.2
Desmoplastic melanoma. A painful and indurated subcutaneous nodule in or near the scar from previous excision usually represents a sign of recurrence
Pathology
The tumor is characterized by a diffusely infiltrative spindle cell proliferation arranged in poorly formed fascicles accompanied by marked interstitial fibrosis and punctuated by collections of lymphocytes (Figs. 46.3 and 46.4). The poorly demarcated neoplasm usually involves the whole dermis, and it frequently extends into the subcutaneous fat. Involvement of skeletal muscle or underlying bone can be found at the time of diagnosis. Nerve involvement is a commonly associated feature and sometimes it may be very marked in the neurotropic variant of DM.



Fig. 46.3
Desmoplastic melanoma is often a deeply infiltrative tumor at presentation

Fig. 46.4
The tumor is characterized by a spindle cell proliferation arranged in poorly formed fascicles accompanied by marked interstitial fibrosis and punctuated by collections of lymphocytes
The melanocytes are nonpigmented spindle cells and usually have a bland appearance with slightly pleomorphic and hyperchromatic nuclei, inconspicuous nucleoli, and low mitotic activity (Fig. 46.5). However, at least in some foci, there are cells with higher degree of cytologic atypia (Fig. 46.6). Based on the degree of desmoplasia and cellularity, DM has been classified by Busam et al. into two histopathologic subtypes. The pure variant (pDM) is typically paucicellular and has prominent desmoplasia. The mixed type (mDM) is more cellular than pDM and comprised of areas of conventional melanoma in a background of classic paucicellular DM. Early recurrent tumors are frequently paucicellular and may be difficult to distinguish from scar tissue. The overlying epidermis may show features of melanoma “in situ” or of a melanoma with underlying regression, but in many cases, no such in situ changes are detected (Figs. 46.7 and 46.8).





Fig. 46.5
The neoplasm is often deceptively bland in appearance

Fig. 46.6
In some foci, cells with big hyperchromatic and pleomorphic nuclei can be found

Fig. 46.7
The overlying epidermis may show features of melanoma “in situ”

Fig. 46.8
Features of melanoma with underlying regression can also be found
Immunohistochemically, DM expresses S-100 protein, NSE (neuron-specific enolase), vimentin, NKI/C3 (CD63), and p75NGF-R (nerve growth factor receptor) (Figs. 46.9 and 46.10). Melan-A (MART-1) and MITF (microphthalmia transcription factor) are variably positive and with limited value. HMB45 is usually negative. SOX10 is a useful marker, especially in differentiating persistence or recurrence of DM from scar.